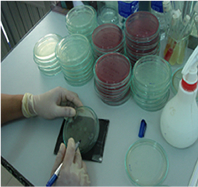

(1)We are confident in sending to your dining tables Safe and Secure Foods
At the beginning of 2008 we have got HACCP certification. Evertrust Foods's products are processed at our factory where the hygiene management is conducted based on severe HACCP standards. Scrupulous management is conducted every single day by locally based Japanese senior staffs from raw materials buying, processing to the loading of finished products. We send to you not only quality that be felt by five-senses as color, taste, smell… but also quality of safe foods. We ETF want to practice those certain things.
*HACCP (Hazard analysis and critical control points)
HACCP is a systematic preventive approach to food safety from biological, chemical, and physical hazards in production processes that can cause the finished product to be unsafe, and designs measurements to reduce these risks to a safe level.

(2)We bring products which are passed hygiene examinations.
We do microbiological examinations on all items before loading. Because, Evertrust Foods wants to bring to our customers just only safe and secure products which are passed microbiological examinations. In order to assure safe quality, all of our staff who concern to products must practice quality control.
Therefore a laboratory was established in factory to catch-up and feedback the result speedily. Hygiene examinations are not only checking quantity of bacteria but doing sensory examination of color, smell, taste… as well. Because we are professional examiner of Tuna, we can catch even very tiny unusual which are impossible to see numerical value.